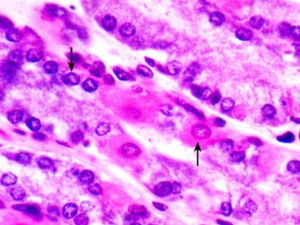
主細胞

胃
主細胞 (chief cell):又稱胃酶細胞(zymogenic cell),分布在胃底腺的下半部。細胞呈柱狀,核圓形,位於基底部。細胞基部呈強嗜鹼性,頂部充滿酶原顆粒,但在普通固定的染色體標本上,顆粒多溶失,使該部位著色淺淡。顆粒內含胃蛋白酶原(pepsinogen),以胞吐方式釋放出後,被鹽酸激活成具有活性的胃蛋白酶,參與對蛋白質的初步消化。
甲狀旁腺
主細胞:數量最多,呈多邊形,核圓, 居中,HE染色胞質著色淺。主要分泌 甲狀旁腺激素(parathyroid hormone),主要作用於 骨細胞和破骨細胞,使骨鹽溶解,並能促進腸及腎小管吸收鈣,從而使血鈣升高。在 甲狀旁腺激素和降鈣素的共同調節下,機體維持血鈣的穩定。
腎
遠曲小管和集合管的上皮的主細胞。功能:重吸收鈉離子(主要通過鈉離子通道)和水,分泌鉀離子。
主細胞
主細胞